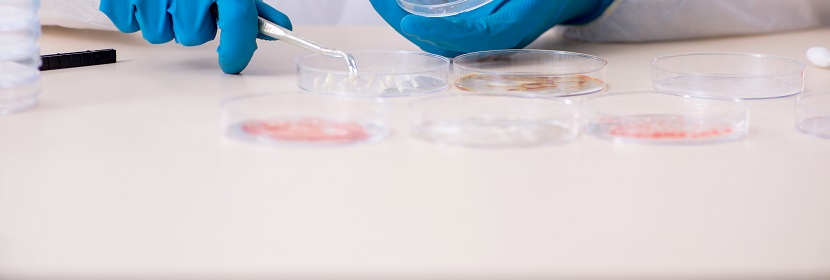
輪胎用聚酯浸膠簾子布檢測

電動自行車內胎檢測
健明迪檢測提供的電動自行車內胎檢測,檢測項目 規格尺寸、外觀、最大使用壓力、密封性、裝配扭矩、密封帽的密封性、大徑,檢測標準 GB/T31547-2015電動自行車內胎 GB/T528硫化橡膠或熱,具有CMA,CNAS資質。

電動自行車內胎檢測 檢測項目
規格尺寸、外觀、最大使用壓力、密封性、裝配扭矩、密封帽的密封性、大徑、中徑、小徑、膠座邊緣厚度、橡膠與金屬體的粘著強度、橡膠與金屬體的附膠率、
扯斷伸長率、接頭拉伸強度、膠座氣門嘴底座與胎身的粘合強力、機床試驗里程、等等
電動自行車內胎檢測 檢測介紹
電動自行車內胎都用橡膠制成,呈圓環狀,其上裝一只氣門嘴,通過氣門嘴給內胎充氣,內胎所充氣壓的大小影響車輪剛度、緩沖性能和輪胎壽命的主要因素。內胎的尺寸規格由配套使用的外胎決定,內胎主要質量指標是氣密性。
電動自行車內胎檢測 檢測標準
GB/T 31547-2015電動自行車內胎
GB/T 528硫化橡膠或熱塑性橡膠拉伸應力應變性能的測定
GB 1796.1輪胎氣門嘴第1部分:壓緊式內胎氣門嘴
GB1796.2輪胎氣門嘴第2部分:膠座氣門嘴
GB/T31546電動自行車輪胎
GB/T31548電動自行車輪胎系列
GB/T31549電動自行車輪胎性能試驗方法
GB/T 528硫化橡膠或熱塑性橡膠拉伸應力應變性能的測定
GB 1796.1輪胎氣門嘴第1部分:壓緊式內胎氣門嘴
GB1796.2輪胎氣門嘴第2部分:膠座氣門嘴
GB/T31546電動自行車輪胎
GB/T31548電動自行車輪胎系列
GB/T31549電動自行車輪胎性能試驗方法